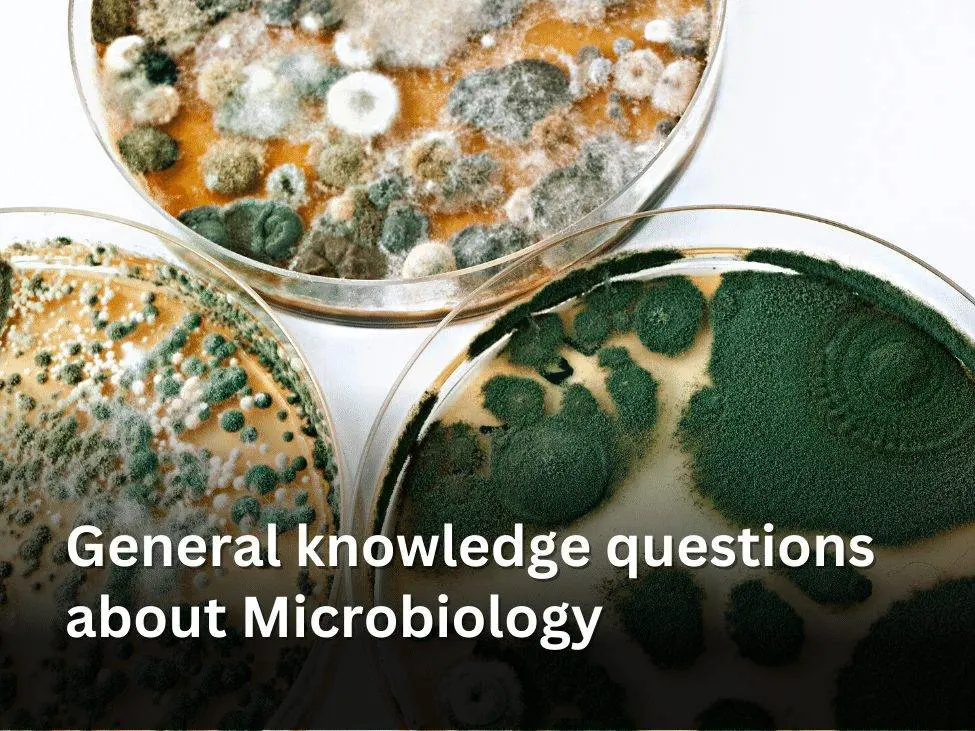
General knowledge questions about Microbiology

Microbiology is the study of microorganisms which include fungi, bacteria, viruses, and a few types of parasites. Microbiology is a quite broad discipline that covers multiple important areas such as virology, mycology, parasitology, etc. Microbiology also includes the study of certain viruses which cannot technically be classified as living organisms. However, it can be divided into two core branches which are known as pure and applied. Moreover, microbiology can be separated by taxonomy, which classifies various microbes. Are you willing to learn a little more about Microbiology or do you want to take a quick test and see how much you know about Microbiology? Well, it is always fun to learn something online. We are here with another fun yet knowledgeable quiz to test you. So, scroll down to take this amazing general knowledge question about Microbiology.
Good Luck!
1. What are the branches of Microbiology?
Answer: Well, Microbiology can be divided into 2 main branches that are pure and applied. They can further be divided into 4 categories which include immunology, microbial genetics, medical microbiology, and biotechnology.
2. Who is known as the father of Microbiology?
Answer: Van Leeuwenhoek is the father of Microbiology
3. What did Van Leeuwenhoek discover?
Answer: Van Leeuwenhoek discovered both bacteria as well as protists
4. Name the five special fields of Microbiology?
Answer: The five special fields of Microbiology include the following:
⁃ Virology: the study of viruses
⁃ Bacteriology: the study of bacteria
⁃ Mycology: the study of fungi
⁃ Immunology: the study of the immune system
⁃ Parasitology: the study of parasites
5. Name the scientist that published a report in 1861 examining the doctrine of spontaneous generation?
Answer: The name of scientist that published the report in 1861 is Louis Pasteur
6. Name the scientist who proved the germ theory of disease?
Answer: Robert Koch
7. Before 1650, it was widely believed that the origin of living organisms was from inanimate materials. What was this myth called?
Answer: This myth was known as spontaneous generation
8. Name the scientist who developed a high-resolution microscope that enabled him to discover and record many microorganisms?
Answer: Antony van Leeuwenhoek
9. What year did the study of microorganisms begin?
Answer: The study of microorganisms began in 1650
10. What were the first bacteria called?
Answer: The first bacteria were known as Cyanobacteria
11. What are the types of microbes in Microbiology?
Answer: Many types of microbes include the following:
-Fungi
-Viruses
-Algae
-Bacteria
-Lichens
-Slime molds
-Prions
12. What “P” term refers to a virus, bacteria, or other agent that causes disease?
Answer: It is Pathogen
13. Amino acids are organic compounds that unsurprisingly contain the amine functional group. Name another functional group that always contains it.
Answer: The other functional group is known as Carboxyl
14. What’s the term for an organism that loves and thrives in an environment with a pH under 4?
Answer: Acidophils
15. Name the contagious disease that causes symptoms including the formation of small white abrasions called Kolpiks’ spots and is also known as rubeola and morbilli.
Answer: The contagious disease known as Measles
16. Name the substance causes an immune response in the body that leads to the production of antibodies?
Answer: Antigen
Related: Highest-paying jobs after a degree in Clinical Psychology